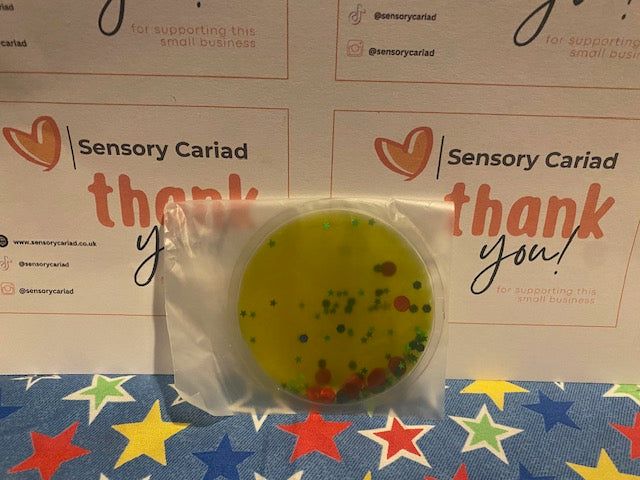
Squidgy Glitter Circles
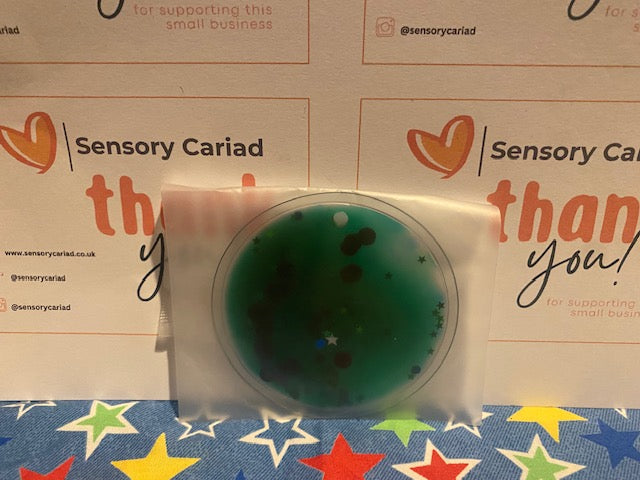
Squidgy Glitter Circles

1
/
of
2
My Store
Squidgy Glitter Circles
Squidgy Glitter Circles
Regular price
£2.00 GBP
Regular price
Sale price
£2.00 GBP
Unit price
/
per
Taxes included.
Couldn't load pickup availability
Fidget circles, each filled with a vibrant coloured liquid and glitter filled circle. Squish, bend, squash, push and feel. Visually entertaining, tactile and stress relieving. Helps with relaxation and concentration.
Colour chosen at random
Features:
Size: 29.5 x 10cm diameter.
Share